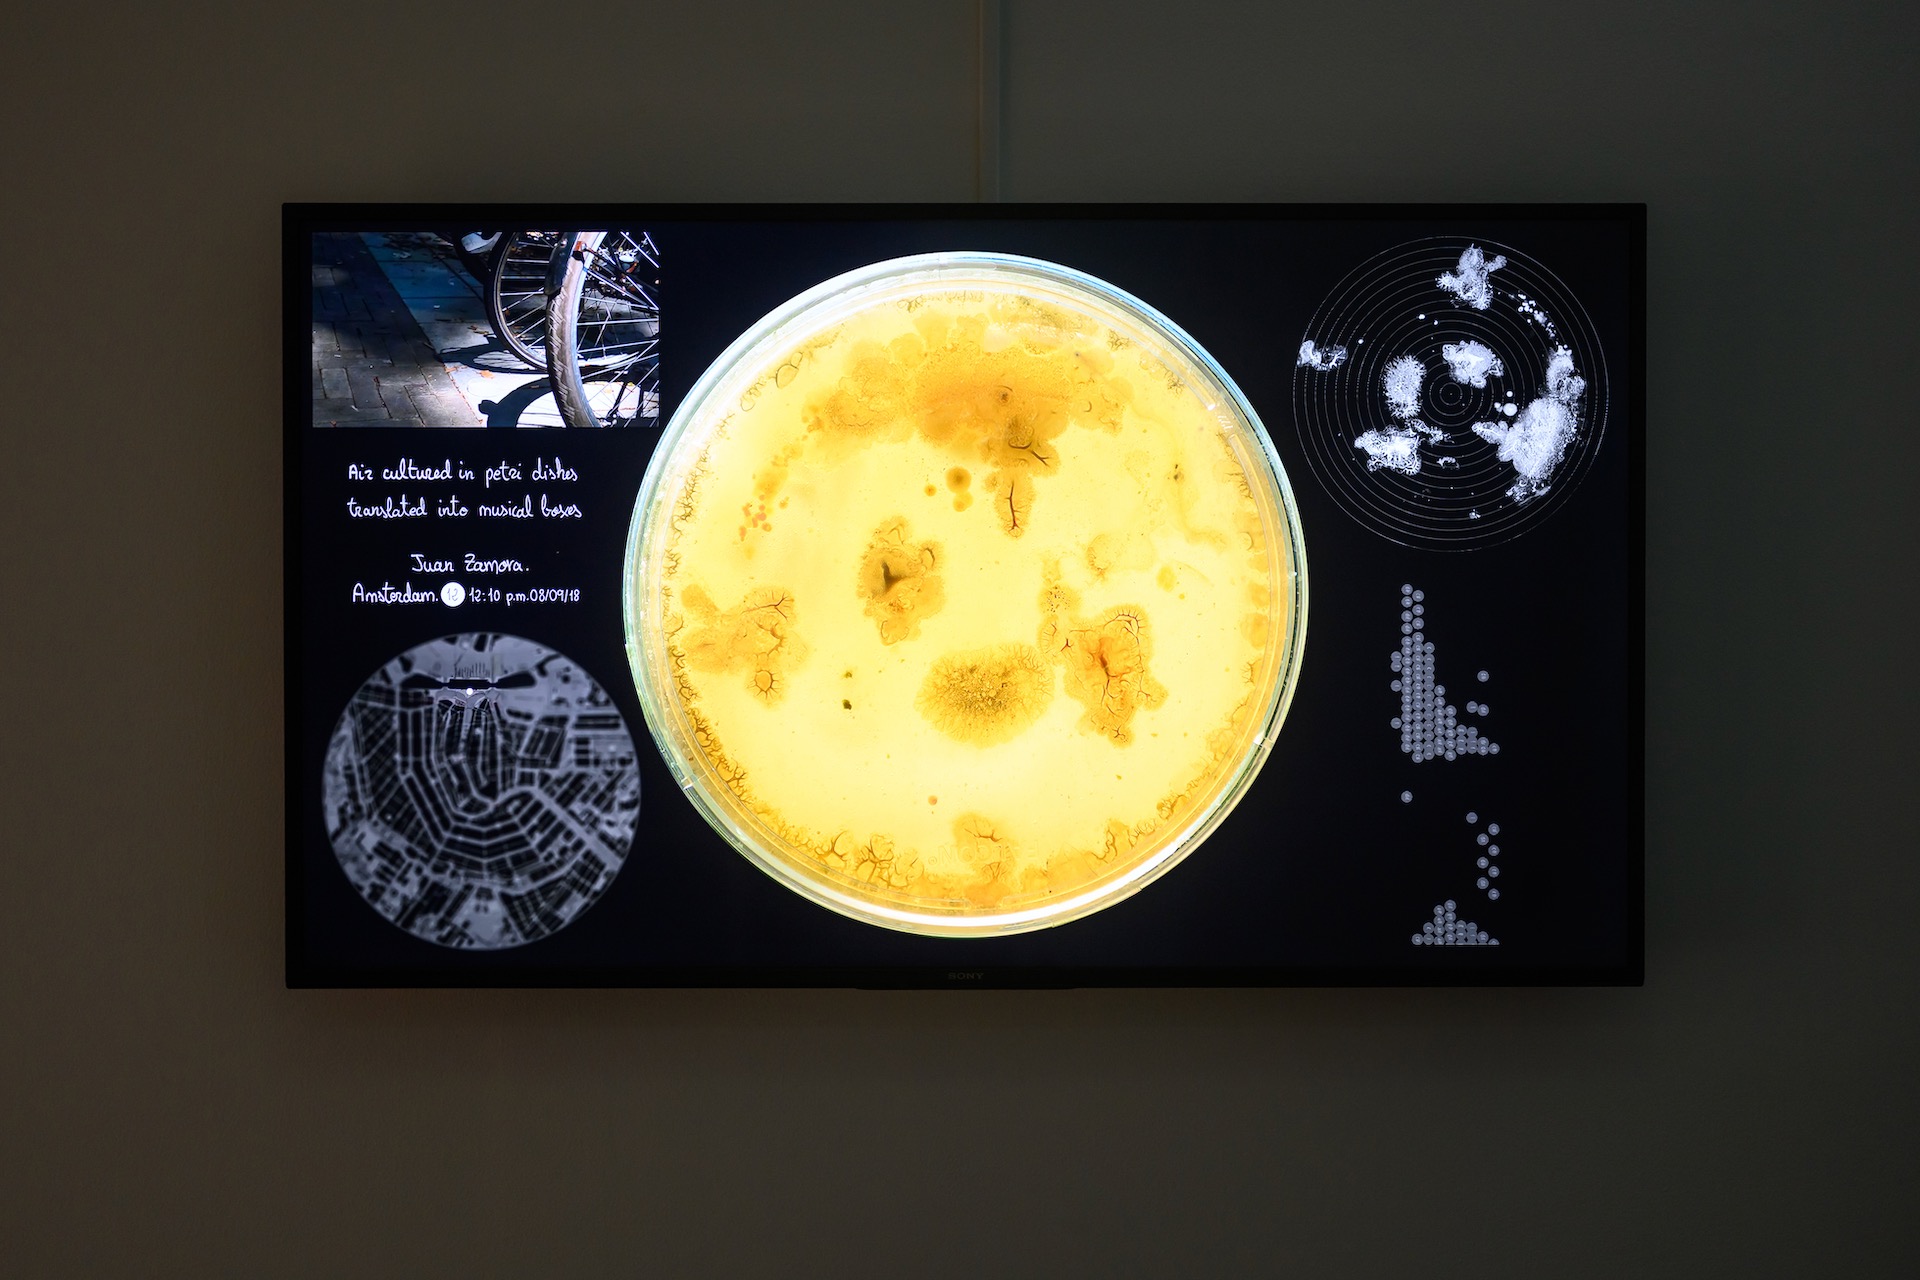

台北當代藝術館(簡稱「當代館」)在去年迎來開館二十週年慶,並為此推出一系列策展:從「歷史・當代」啟動「歷史」與「當代」的往返對話,到「為了明天的進行式」想像下一個20年的多元未來,再到「過站不停」於線性的發展進程中撿拾異質的記憶碎片;而上週盛大開幕的「蓋婭:基因、演算、智能設計與自動機_幻我;它境」(簡稱「蓋婭」)作為該系列最後一檔展覽,亦接續這般交疊揉雜的時間性辯證,從當代科技藝術發展的歷史化與關係辯證出發,遙想更廣大浩瀚的未來烏托邦。

未來的「蓋婭」
在當代館二十週年的前一年,經典的科幻電影《銀翼殺手》(Blade Runner)25週年數位重製版正式登入國內院線,而2020年正是這部電影在1982年所假想的時空背景。片商另在該片首映25週年推出續做《銀翼殺手2049》(Blade Runner 2049,2017),近期更宣布系列新作再將時序往後推移至2099年;當「未來」已不斷到來時,「蓋婭」一展恰隱隱回應著「歷史・當代」對當代已成歷史的提問,意即在時間洪流不斷刷洗下,我們如何對新的世界與生命面貌進行重新認識?
展覽首先回到希臘神話找尋靈感,主標題以大地之母「蓋婭」,指向世界與生命的起源。不過,相較神話總將答案與詮釋安置在無法企及的遠古中,策展人沈伯丞指出,英國思想家法蘭西斯.培根(Francis Bacon)在《新亞特蘭提斯》(The New Atlants,1626)已將烏托邦或理想世界的想像投向未來,強調人類可透過「科學、科技技術與藝術」實現美麗新世界。「蓋婭」透過新神話的典範轉移,除為展覽開啟未來生命與古典神話間的對話,貫串多件作品與策畫展呈中,更旨在「投射出『科技』做為新『創世』的母體狀態」。
沈伯丞近年發起「再・創世」(Cybernetic)藝術計畫,已嘗試從演化控制學(Evolutionary Cybernetic)的理論基礎,探討各式新知識技術所構成的未來生命圖像,並曾於敝站企劃專題發表。他在本次展覽中,選擇了二十世紀下半以降,對生命思考產生最大衝擊的四個不同科學技術——基因工程、演算法、智能設計與自動機(機器工學),提問其如何成為現當代的「蓋婭」,並共同勾勒出複雜的網絡系統,重新打造與定義未來的世界與生命面貌。
延伸閱讀|【專題】《再.創世》

科技與藝術
不過,從相關研究調查走向本次於當代館的藝術展演,策展人更重於思辨藝術創作在未來科技發展、生態環境與生命政治等討論與推進中,所可扮演的創造性角色位置。沈伯丞表示自己2014至2017年間,曾於《科學人》雜誌上固定發表專欄,即不斷省思科學與藝術之間的互動關係,以及為何會有這麼多新的藝術類型陸續誕生?
沈伯丞闡述自己相信科學提供了關於真理的事實,藝術卻提供了關於真理的意義。亦即當前者被藝術家應用、轉化成藝術形式之後,重點已不在於工具化的功能想像,更關乎藝術家如何跳脫嚴謹的邏輯辯證,省思與回應新的科學知識及科技技術進行對於文明的衝擊,且透過對審美跟精神性等的探究,顯現人類透過技術對於自身想像的「幻我」,以及嘗試打造的理想「它境」。沈伯丞闡釋,科學唯有透過藝術,方能真正開啟大眾對更寬廣的生命意義的探索與未來想像,甚至再誘發新科技的出現。
不過,如同沈伯丞所言,藝術創作的重點並不重於尖端科技的追求,故縱然本次展覽的一大亮點,為國內公立美術館首度與參展藝術家(黃新)聯手推出限量門票販售,並在實體展場中展出數件NFT作品,「蓋婭」卻沒有急於投身對嶄新科技技術乃至藝術類型的追求,而是透過前述的神話主題與四個子題,循序漸進地鋪陳當代科技藝術隨著技術演進的歷史縱深。

生命構成與自然世界的現形
首先,一樓的各展間重於生命構成狀態與自然世界面貌的「現形」,亦即新的科技視野如何提供了新的觀看語彙、方式、系統與介面。展覽入口處勞夫.貝克(Ralf Baecker)的《網路的自然史/軟機械》(A Natural History of Networks / Soft Machine,2021)即透過攝影機捕捉液態金屬合金與化學溶液在導入電流下產生的混合現象,並以演算法創造一個動態流體的微觀世界,模擬地球生命誕生緣起的化學變化與能量交換,進而再現網路與雲端世界中全新的創世紀過程;接著,克雷格.布洛(Craig P. Burrows)的「UVIVF植物攝影」系列(2017-2020)透過紫外線誘發可見的螢光攝影,顯影我們肉眼不可見的植物訊息,賦予人類更細微的生命觀察與認識;而相較於前二者以科學技術模擬或觀察自然演化,「UVIVF」對面玻璃窗中鄭先喻的《生命遊戲》(2022),面向1970年發明的細胞自動機,如何從對生命演化初期的模擬研究,逐步踏入藝術創作的美學範疇。而這般演化更迭又在科技技術的發展中持續加速,如同窗內的機器手臂在演算規則控制下,將細胞的圖像進行塗繪與抹去,反反覆覆。


胡安・薩摩拉(Juan Zamora)的《氣態文化》(Air Cultures,2018)則再將「UVIVF」歌德式科學方法的視覺觀察,推進至聽覺感知層次,將不可見的微生物聚落之蔓延轉化為樂譜上的音符;他並在《樹棲》(Habitar un árbol / Cantar la tierra,2021)中反思科技技術的發展,如何改變人們與自然世界的互動關係,辯證真實與數位世界的落差:當前者中的樹木因都市開發而被砍伐後,卻以影像持續留存於後者的Google Street View中,作為實體消失後「此曾在」的證據。而展場中以土壤排成的QR CODE,在此彷彿作為對自然的悼念般,昭示螢幕介面已成為當代世界認識的新途;薩摩拉另外在《移植》(Transplant,2017-2021)中展現了時下醫療技術,如何透過脫細胞技術,保留植物葉片上的有機組織結構,再注入培養的血液細胞,用作如心臟等器官治療上。

《移植》中不同生命體經由生物科技技術的交互轉化,除開啟共構的新關係想像,也直指人們對自身生命觀看思考的轉變;保羅.汎諾斯(Paul Vanouse)的《美國計畫》(America Project,2016)即將科技技術拓展至真實世界中的政經治理探討。他將蒐集而來的唾液樣本混和在狀似噴泉裝置的容器中,集體融合製作出具有權力象徵性的DNA指紋圖像投影,藉此一權力的顯像,批判基因工程對個人隱私與生命倫理的威脅。

艾美.卡爾(Amy Karle)則在三件作品中,進一步展示藝術對醫學身體與身體探測的轉化。拜解剖學及影像與醫療技術的進展,人類對於身體內部的觀看、洞察能力與層次,早已不可同日而語。《內在集成》(Internal Collection,2016-2017)將人體內如肺葉、動脈、淋巴腺、結締組織等皮膚表層下的內在身體系統,運用3D雕塑外部化,製成肌膚之上的服飾。該作其實並非藝術家的空想,不禁讓人聯想起名模貝拉.哈迪(Bella Hadid)在去年的坎城影展上,即身穿一件「Maison Schiaparelli」的訂製服,於胸前展示肺葉形狀的珠寶。
除了具象的視覺再現,《生物回饋》(Biofeedback Art,2011)也透過電子探測器連結身體,轉譯聲音與色彩輸出,彰顯身體在醫學上,已為心電圖、腦電波等醫療儀器轉變為數據化訊號。不過,藝術家在此將探測器對準的是「脈輪」位置,更嘗試開啟古代東方神祕學中的能量身體與西方科學技術之間的交互對話;如此將當代醫療科技技術昇華至與心靈層次的探索,更體現於卡爾的《鹽礦坑中的表演》(Performance In Salt Mine,2018)中。藝術家來到人類所開鑿出最深、最大的洞窟「波蘭維利奇卡鹽礦」(Kopalnia soli Wieliczka),透過腦電波感測器測量大腦在冥想下的電波頻率,並在其頭頂上投影出圖像與聲效。藝術家在將自身幻化為科技時代裡的「蓋婭」身影的同時,亦回望著人類演進的關鍵:人類之所以為人類,即因在遠古洞穴中創造了藝術,而創發了心靈活動。此一精神性的儀式可謂為「蓋婭」展覽的一樓展間,做了承先啟後的總結。



科技文明的連續與斷裂
帶著科技技術發展下的心靈探索來到二樓,此一問題意識接著在幾件作品中,開啟對數位治理之於文明的雙面性思考,在「美麗新世界」般歌舞昇平的許諾中,更全面地省思未來:陳乂的「地衣_」計畫(2021)首先以3D掃描技術記錄從莫三比克移居柏林的遊民,影像的碎片展示了「科技之外」的人們,如何適應高速發展的科技社會,宛若地衣一般依附乃至佔領城市邊緣,一方面展現人類文明在地表上的拓展狀態,卻也呈現了科技發展下的排除機制;而于軒的「克萊因‧赫茲」系列(2017)不再對準特定技術,借用歷史人物之名,虛構出一位科學家所遺留下來的失敗實驗室場景。他結合寫實繪畫與擬真裝置,勾繪出鋼鐵機件腐蝕的質感樣貌,以及散落在地的儀器及石化的生物骨骸,對科技的末世氛圍進行臨場再現。兩位藝術家除了在議題上面向科技的失敗與無效,陳乂地毯式的掃描拍攝與于軒以純然繪畫與雕塑構建成的多重建構工序,都發揮了藝術的作用,在美學形式上呈現出文明感性的暗面。


吳梓寧的《捕蠅草人改造計畫01》(2018)則從性別角度切入,嘗試引用「捕蠅草消化液」與人類性功能相似之組織結構,呈現生物基因混種改造與人工器官培養的模擬,並藉由捕蠅草開合與女性生殖器的對照,翻轉植物在生物階層中的低等歸類,以及其作為女性被動的象徵迷思連結;她另在《網路後世—基因求籤販賣機》(2016)中,探問「宗教命定論」的八字,如何在基因編輯技術的發展下,進階成「科技命定論」惟DNA是問的新迷信。藝術家也在展間外以染色體圖像,擬仿哥德式教堂的彩繪花窗,象徵基因工程上升至宗教信仰的權力擴張。

古典的宗教信仰於當代或未來科技中的延續或變形,也可見於黃贊倫的作品中。《神柱》(2020)與《神轎》(2019)中挑高、懸空的廟宇飛簷及華麗精細的雕塑裝飾,皆為藝術家改以積體電路板等零件構成,神聖之聲透過錯綜的電線交錯、連結,取而代之的是無線電科技的訊號傳輸,乃至互動式的程式設計;而《不滅》(2019)影像裡的人物紛紛以吹蠟燭般向螢幕外的燭檯造型燈吹氣,則反映數位身分的複數狀態,如何挑戰傳統的生死觀念;《副本》(2015)亦以人類飲食文化中的食補觀念,展現慾望、生存意志以及自我認同的反覆裂解、增生。



如同科技技術的往前突破,精神信仰與心靈活動亦在其中不斷尋找新的轉化與寄託,吳梓寧與黃贊文在此提醒人類文明進程的歷史連續性——未來總是連結著過去。而這也成了最後幾件作品的重要關注。黃裕雄的作品將展覽從實體的物理與生物世界,帶向數位訊息社會的討論。他透過機器學習與自然語言處理,將自己記錄日常的文字和聲音資料庫,交予電腦進行再創作:《我跟你說一個故事》(2020)以不同的語境重新對其解碼,藉此提問故事乃至真實的全貌為何;「失語症」系列作品(2019)則將前作中所彙整的文字資料,透過電腦程式運算,生產出新的幾何圖像。當藝術家為人工智慧與演算法賦予創作者的角色時,這樣的心智狀態究竟是否取代而成為了藝術家?而當文字語言交由其編碼與解碼後,人類又是否還能找到識讀的途徑?抑或我們在訊息超載的媒體環境下,是否皆早已患上失語症?
延伸閱讀|繪畫於數位藝術中如何魂牽夢縈?「編碼與解碼—黃裕雄個展」中媒介與個人生命的雙重回返


即時生成的活作品
黃裕雄作品為人類與人工智慧、演算法的共作與主客關係拋出諸多哉問,但在近來生成藝術大行其道下,實體與數位的斷裂卻為日漸消弭,二者的共時性連結為愈發強化,最後三位藝術家作品,跨入近期最熱議的NFT範疇,即展現了「即時性」與「真實時間」等概念,儼然已成為藝術創作中重要的操作基礎。首先,臺灣首位登上NFT藝術殿堂「Art Blocks」的藝術家王新仁(阿亂)的「地誌龐克」系列作品(2021),雖以五個真實空間的地理經緯度所構成,卻依觀者所在的錢包位址,而即時性地生成全新的地景。藝術家在此承襲「龐克」文化的叛逆,嘗試在數位世界中被,挑戰與質疑現有世界下因著政治、經濟、文化、種除、意識形態等疆界劃分與地理空間概念。
「地誌龐克」系列-2.jpeg)
而隨著加密藝術交易市場的蓬勃活絡,黃新三件作品則更直接地使用NFT的公開交易資料進行創作,嘗試回應此一文化趨勢,並創發藝術家所期許的「活著的作品」:《綻》(2021)即時撈取Tezos鏈上Hic et nunc賣場的交易資料,當NFT交易產生時,影像上即會綻放一發煙火,其造型和交易的金額有關,顏色則隨著買家、賣家的錢包地址而改變。銀幕在此成了一巧妙的結界:數位世界的煙火雖只發生於影框內,觀眾卻也得在實體物理空間中,隨著影中的動畫人物背影一同觀賞;該作同時也隨煙火標示出相關出交易資訊,文字卻在展場中超越了既有的物理維度,溢出螢幕的2D平面。觀看與展呈的設計在在辯證著實體物理空間與雲端數位空間的並存與界線,乃至跨越的空間想像。
黃新另2件NFT作品《100HEN – NOT WITHOUT YOU》(2021)、《100HEN – NOT WITHOUT YOU(頭像版)》(2021),則由10×10的格子組成,各自撈取作品持有人名字、持有人的頭像,並根據每個人持有的作品數量,改變格子的大小。由於仍在Hic et nunc賣場上交易中,該作在當代館展覽現場的樣貌亦將隨之改變。除了作品本身宛若動態的蒙德里安(Piet Cornelies Mondrian)畫作,策展團隊亦將二者高掛於空中。當實體物理空間的觀眾聚集於下、抬頭仰望時,宛若重現巴洛克時期的崇高般,揭露NFT交易背後的活動動態。

展覽最末由著名的NFT藝術家麥特・德洛里耶(Matt DesLauriers)的《子午線》(2021)收尾。該作看似是水印木刻版畫,卻不再有可參照的地景。藝術家以編碼指令的密集集合所發展出的演算法,機械性地編織出微小的彩色筆觸,並以此逐漸形構出的風景地形,而每一次的執行都會產生全新的版本。沈伯丞感性地總結道,當本作完整地將演算法當作藝術創作的工具時,體現了未來的藝術創作,或許不再需要手工基礎,更多地仰賴各類科技技術。而當新的知識與技術成了藝術表現的技巧,並在其中討論其之於美學形式乃至人類的意義時,這或許就是「前衛藝術」的閃現的時刻。

蓋婭:基因、演算、智能設計與自動機_幻我;它境
展期|2022.02.12 – 2022.04.24
地點|台北當代藝術館
地址|台北市大同區103長安西路39號
童詠瑋( 52篇 )追蹤作者藝評人、獨立編輯。關注橫跨視覺、表演、影像與數位藝術等領域。曾任《典藏ARTouch》編輯、絕對空間展場經理,參與《Fa電影欣賞》、《藝術觀點ACT》執行編輯,書寫另也散見於《典藏.今藝術》、《臺灣數位藝術網》、《放映週報》等平台。紀錄片研究論文曾獲世安美學論文獎。現主要研究旨趣為影像理論、左翼文藝、媒介研究、媒體行動主義等。E-mail: tungyungwei@gmail.com